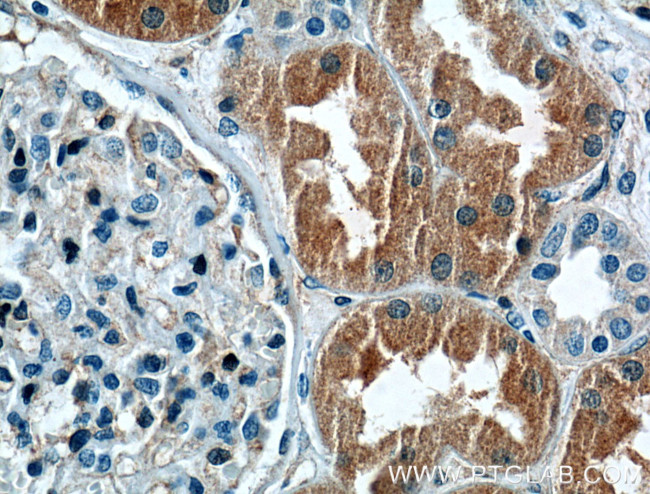
CLIC4 Antibody in Immunohistochemistry (Paraffin) (IHC (P))

Search
Proteintech
CLIC4 Polyclonal Antibody
{{$productOrderCtrl.translations['antibody.pdp.commerceCard.promotion.promotions']}}
{{$productOrderCtrl.translations['antibody.pdp.commerceCard.promotion.viewpromo']}}
{{$productOrderCtrl.translations['antibody.pdp.commerceCard.promotion.promocode']}}: {{promo.promoCode}} {{promo.promoTitle}} {{promo.promoDescription}}. {{$productOrderCtrl.translations['antibody.pdp.commerceCard.promotion.learnmore']}}
产品信息
12298-2-AP
种属反应
宿主/亚型
分类
类型
抗原
偶联物
形式
浓度
规格
纯化类型
保存液
内含物
保存条件
运输条件
产品详细信息
Immunogen sequence: MALSMPLNG LKEEDKEPLI ELFVKAGSDG ESIGNCPFSQ RLFMILWLKG VVFSVTTVDL KRKPADLQNL APGTHPPFIT FNSEVKTDVN KIEEFLEEVL CPPKYLKLSP KHPESNTAGM DIFAKFSAYI KNSRPEANEA LERGLLKTLQ KLDEYLNSPL PDEIDENSME DIKFSTRKFL DGNEMTLADC NLLPKLHIVK VVAKKYRNFD IPKEMTGIWR YLTNAYSRDE FTNTCPSDKE VEIAYSDVAK RLTK (1-253 aa encoded by BC012444)
靶标信息
Chloride channels are a diverse group of proteins that regulate fundamental cellular processes including stabilization of cell membrane potential, transepithelial transport, maintenance of intracellular pH, and regulation of cell volume. Chloride intracellular channel 4 (CLIC4) protein, encoded by the CLIC4 gene, is a member of the p64 family; the gene is expressed in many tissues and exhibits a intracellular vesicular pattern in Panc-1 cells (pancreatic cancer cells).
仅用于科研。不用于诊断过程。未经明确授权不得转售。
篇参考文献 (0)
生物信息学
蛋白别名: chloride channel of intracellular membranes; chloride intracellular channel 4 (mitochondrial); chloride intracellular channel 4 like; Chloride intracellular channel protein 4; CLIC4; DKFZP566G223; epididymis secretory sperm binding protein; FLJ38640; Glutaredoxin-like oxidoreductase CLIC4; Intracellular chloride ion channel protein p64H1; mc3s5/mtCLIC; mitochondrial chloride intracellular channel 4; unnamed protein product
基因别名: CLIC4; CLIC4L; D0Jmb3; H1; huH1; mc3s5; MTCLIC; p64H1; TU-74
UniProt ID: (Human) Q9Y696, (Mouse) Q9QYB1, (Rat) Q9Z0W7
Entrez Gene ID: (Human) 25932, (Mouse) 29876, (Rat) 83718